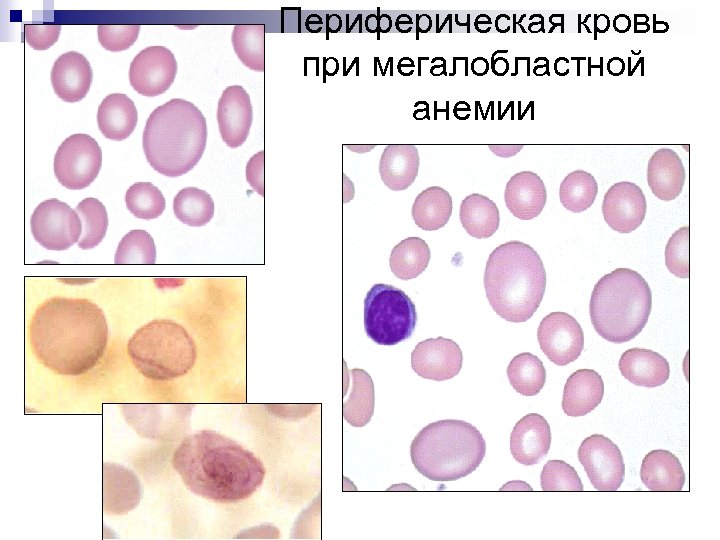
Периферическая кровь при мегалобластной анемии

f9ecdb6c5615610137011814d2e07bf4.ppt
- Количество слайдов: 86

Лабораторная диагностика анемий Кафедра клинической лабораторной диагностики РМАПО ПОЧТАРЬ М. Е. 2007 год

Кинетика эритрона.

Под термином "анемия" понимают состояние, характеризующееся снижением уровня гемоглобина и количества эритроцитов в единице объема крови. От истинной анемии следует отличать гидремию (гемодилюцию, гиперволемию), обусловленную разжижением крови и увеличением объема плазмы (при беременности, сердечной недостаточности, трансфузии кровезаменителей). Гемодилюция сопровождается снижением количества эритроцитов и содержания гемоглобина в единице объема при полном сохранении их общей массы. Диагностическиt критерии анемии: у мужчин у женщин RBC < 4, 0 млн/мкл, Hb < 130 г/л, Ht < 40 % RBC <3, 8 млн/мкл, Hb < 120 г/л, Ht < 36 %

Разделение анемий по патогенетическому принципу. Анемии вследствие нарушения эритропоэза: n n n гипохромные анемии (ЖДА, анемии связанные с нарушением синтеза и утилизации порфиринов ) мегалобластные анемии гипопластические анемии Анемии вследствие повышенного разрушения эритроцитов (гемолитические анемии) Анемии, обусловленные кровопотерей (острые постгеморрагические анемии)

Параметры, характеризующие красную кровь.

Параметры, характеризующие красную кровь.

RBC-гистограмма

Нормальная RBCгистограмма

Снижение Hb MCV менее 80 fl MCH менее 26 пг MCHC менее 320 г/л RDW норма или увеличен Микроцитарные гипохромные анемии ЖДА Нарушение синтеза и утилизации порфиринов, Гетерозиг. талассемия и др. MCV в пределах нормы MCHC в пределах нормы RDW обычно в пределах нормы MCV более 100 fl MCH более 32 пг MCHC в пределах нормы RDW увеличен Нормоцитарные Нормохромные анемии Макроцитарные нормо- или гиперхромные анемии Анемии при заболеваниях почек Гипопластические анемии Острая постгеморрагическая анемия, АХЗ В 12 -дефицитная анемии Фолиеводефицитная анемия Анемия при хронических заболеваниях печени, АИГА

Дифференцировка клеток эритропоэза

Исследование ретикулоцитов используется для: Ø оценки активности эритропоэза при состояниях, сопровождающихся гемолизом или кровопотерей; Ø детекции нарушения регенераторной способности костного мозга при дефиците железа, витаминов В 12, В 6, фолатов, меди и мониторинга соответствующей терапии; Ø оценки состояния эритропоэза на фоне лечения эритропоэтином; Ø оценки способности костного мозга к регенерации после цитотоксической терапии и трансплантации костного мозга; Ø оценки восстановления синтеза ЭПО после трансплантации почки; Ø допингового контроля у спортсменов (прием ЭПО – Ret>2, 4%, Ht>47% )

Принципы анализа ретикулоцитов в гематологических анализаторах ØИспользование нефлуорохромной краски (новый метиленовый синий) осаждающей РНК в ретикулоцитах GEN-S (Beckman-Coulter), Cell-Dyn 3500 и 3700 (Abbott Diagnostics) ØИспользование флуоресцирующих красителей (тиазол оранжевый, тиофлавин Т, полимитин, цианин CD 4 K 530, акридин оранжевый, оксазин 750 и др. ) - Sysmex XE-2100, Sysmex XT-2000 i, Bayer Advia 120, Cell-Dyn 4000, ABX Pentra 120 Retic

показатели ретикулоцитов: · классические : RET% - относительное количество ретикулоцитов; RET# - абсолютное количество ретикулоцитов · объемные : MRV (Mean Reticulocyte Volume) – средний объем ретикулоцитов, (фл); MSCV (Mean Sphered Cell Volume) – средний объем сферических клеток (средняя величина объемов сферулированных эритроцитов после воздействия закисленного гипотонического раствора), фл

Распределение ретикулоцитов по количеству и степени зрелости при некоторых гемалотогических заболеваниях

Показатели, отражающие содержание гемоглобина в ретикулоцитах RET-Y (расчетный показатель размера клеток по среднему значению FSC) или CHr (Bayer Technicon H 2) (норма 28 -32 пг )

Скорректированный подсчет ретикулоцитов (Corrected Reticulocyte Count - CRC) CRC = RET% x Ht/0, 45 Индекс продукции ретикулоцитов (RPI -Reticulocyte production index ) RPI = RET% x HCT 0, 45 (идеальный HCT) x дни циркуляции в крови HCT Эритропоэз эффективен при RPI 2 дни циркуляции Ret в крови 45 % 1 day 35 % 1, 5 days Shift 25 % 2 days 15 % 2, 5 days

Индекс продукции ретикулоцитов

Гипохромные микроцитарные анемии

Железодефицитная анемия - самое распространенное заболевание во всем мире. По данным ВОЗ зарегистрировано около 1 млрд человек страдающих ЖДА Железо — облигатный биометалл: метаболизм; пролиферация. Распределение железа железосвязывающие белки свободное железо инициация цепных реакций образования свободных радикалов: 1. Перекисное окисление липидов биомембран. 2. Токсическое повреждение белков. 3. Токсическое повреждение клеточного генома

Распределение железа в организме

Всасывание железа в желудочнокишечном тракте Просвет 12 перстной кишки Основные процессы: n Захват Fe 2+ клетками слизистой оболочки тонкой Fe 2+ кишки. из пищи n Окисление Fe 2+ в Fe 3+ на мембране микроворсинок эпителия тонкой кишки. Регуляция ГЕМ n Гиперсидеринемия: комплекс Fe-ферритин удаляется со Неабсорбирослущивающимся ванное Fe кишечным эпителием. n Сидеропения: увеличение скорости всасывания Fe в кровоток, образование комплекса Fe-трансферрин Капилляр Энтероциты тонкой кишки ферритин клетки Мембранный переносчик (DCT 1) Fe 3+ + трансферрин Трансферрин сыворотки Гаптоглобин, гемопексин Fe , теряемое со слущивающимися энтероцитами.

Взаимодействие внутри- и внеклеточного Регуляция • Чем выше пролиферативная активность, тем значительнее экспрессия рецепторов трансферрина (до 800. 000 на поверхности эритрокариоцита). • Чем ниже содержание Fe в клетке, тем выше экспрессия рецепторов трансферрина. • При высокой скорости синтеза рецепторов трансферрина происходит угнетение синтеза молекул ферритина. пулов железа.

Депонирование железа: ферритин и гемосидерин Ферритин (500 к. Да; содержит 15 -20% от общего Fe) n Внутриклеточный протеин — показатель величины запасов железа: кратковременное и длительное депонирование Fe 2+ в тканях. • Основные источники n Показатель степени сывороточного ферритина: острофазового ответа и 1. Моноциты крови деструктивных процессов: 2. Купферовские повышение продукции клетки печени ферритина (инфекция, 3. Макрофаги иммунные комплексы, селезенки. опухоли).

Этиология железодефицитной анемии n Кровопотери : - менструальные кровопотери, беременность, роды, лактация; - кровопотери из желудочно-кишечного тракта : язвенные поражения, опухоли, полипы, дивертикулез, геморрой, глистные инвазии (анкилостомидоз); - кровопотери в замкнутые полости с нарушением реутилизации железа: эндометриоз, легочный сидероз, гломические опухоли; n Алиментарный фактор У детей (растительно-молочная диета) n - недоношенность; - многоплодная беременность; - поздний прикорм; - быстрый рост (повышенное потребление железа) n Донорство n Нарушение всасывания (хронический энтерит, резекция тонкой кишки, дисбактериоз, лямблиоз) n Заместительная терапия р. ЭПО заболеваний ) ( ХПН, анемии хронических

Клиника ЖДА n Скрытый (латентный )дефицит железа СИДЕРОПЕНИЧЕСКИЙ СИНДРОМ: РЕЗКОЕ ВЫПАДЕНИЕ, СУХОСТЬ И ЛОМКОСТЬ ВОЛОС, РАННЯЯ СЕДИНА, УПЛОЩЕНИЕ НОГТЕЙ, ИХ ЛОМКОСТЬ, ТРЕЩИНЫ, ПОПЕРЕЧНЫЕ БОРОЗДЫ, СУХОСТЬ КОЖИ, ГИПЕРКЕРАТОЗ, БОЛЕЗНЕННЫЕ НЕЗАЖИВАЮЩИЕ ТРЕЩИНЫ В УГЛАХ РТА, НА ЯЗЫКЕ, НА ПАЛЬЦАХ РУК И НОГ, ПЯТКАХ ИЗВРАЩЕНИЯ ВКУСОВЫХ И ОБОНЯТЕЛЬНЫХ ПРИСТРАСТИЙ ЧАСТЫЕ ИНФЕКЦИИ, УВЕЛИЧЕНИЕ АДЕНОИДОВ НАРУШЕНИЯ ГЛОТАНИЯ, МЫШЕЧНАЯ СЛАБОСТЬ, СЛАБОСТЬ СФИНКТЕРОВ (НЕУДЕРЖАНИЕ МОЧИ ПРИ КАШЛЕ, СМЕХЕ) ПОЖЕЛТЕНИЕ КОЖИ ЛАДОНЕЙ, ПОДОШВ, НОСОГУБНОГО ТРЕУГОЛЬНИКА, УШЕЙ ЛАБОРАТОРНЫЕ ПОКАЗАТЕЛИ: Hb, RBC, MCV, MCHC, RDW - НОРМА, СЫВОРОТОЧНОЕ ЖЕЛЕЗО - НОРМА ИЛИ СНИЖЕНО, ТРАНСФЕРРИН - НОРМА ФЕРРИТИН – СНИЖЕН Растворимые рецепторы к трансферрину - -повышены

Собственно железодефицитная анемия АНЕМИЧЕСКИЙ СИНДРОМ: слабость, головокружение, сердцебиение, одышка, обмороки СИДЕРОПЕНИЧЕСКИЕ СИНДРОМЫ прогрессируют ЛАБОРАТОРНЫЕ ПОКАЗАТЕЛИ: Костный мозг n Клеточность К/М - Nили n Л/Э - n Преобладают базофильные и полихроматофильные нбл; n оксифильные нбл n Мелкие полихроматофильные нбл

Картина периферической крови при ЖДА (регенераторная фаза) RBC 4. 58 x 1012/л Hb 76 г/л MCV 60. 9 фл MCH 16. 6 пг MCHC 272 г/л RDW 16. 0 % гипохромия , микроцитоз эритроцитов.

Варианты тромбоцитарных гистограмм при ЖДА, полученные на разных анализаторах.


МИКРОЦИТАРНАЯ И ГИПОХРОМНАЯ АНЕМИЯ - НЕ ВСЕГДА ЖЕЛЕЗОДИФИЦИТНАЯ МИКРОЦИТАРНАЯ ГИПОХРОМНАЯ АНЕМИЯ РАЗВИВАЕТСЯ ПРИ НАРУШЕНИЕ СИНТЕЗА ГЕМОГЛОБИНА ВСЛЕДСТВИЕ: n n n НЕДОСТАТКА В ОРГАНИЗМЕ ЖЕЛЕЗА; НАРУШЕНИЕ СИНТЕЗА И УТИЛИЗАЦИИ ПОРФИРИНОВ; НАРУШЕНИЕ СИНТЕЗА ГЛОБИНОВ.

Патогенез анемии, связанной со свинцовым отравлением n n Блокада сульфгидрильных групп в активных центрах 2 -х ферментов, участвующих в синтезе гема: дегидротазы АЛК и феррохелатазы Нарушение синтеза гема увеличение содержания железа в сыворотке отложение его в органах Снижение скорости синтезе -глобиновых цепей Снижение активности К-Na-АТФ-азы снижение концентрации К+ в эритроцитах гемолиз эритроцитов

Анемия, связанная со свинцовым отравлением n Поражение нервной системы - астенизация, головная боль, головокружение, синдром двигательного полоневрита, тетрапарезы ; n Поражение ЖКТ - снижение аппетита, свинцовые колики; n Изменения со стороны крови : - гипохромная анемия, базофильная пунктация эритроцитов, ретикулоцитов, количества эритрокариоцитов, появление кольцевидных сидеробластов; - сывороточного железа, ОЖСС, -АЛК в моче.

Базофильная пунктация эритроцитов периферической крови Кольцевидные сидеробласты

Анемии хронических заболеваний ( АХЗ ) n Инфекционно-воспалительные процессы (острый и хронический пиелонефрит, бактериальный эндокардит, туберкулез, нагноительные заболевания легких, вирусный гепатит) n Неинфекционно-воспалительные заболевания (ревматоидный артрит, болезнь Крона, саркоидоз) n Первичные и метастатические опухоли

Патогенез АХЗ основное значение имеет абсолютный или относительный дефицит эндогенного эритропоэтина (э. ЭПО).

«Анемии хронических заболеваний" (АХЗ). Периферическая кровь. n Анемия чаще носит нормохромный нормоцитарный, реже умеренно гипохромный характер. n Количество ретикулоцитов нормальное или уменьшено. Костный мозг характеризуется: n нормальным или сниженным количеством эритрокариоцитов, n нормальным или повышенным содержанием сидеробластов. Изменения метаболизма железа характеризуются перераспределительным дефицитом железа: n снижение сывороточного железа, ОЖСС, трансферрина, НТЖ n повышение содержания сывороточного ферритина.

Дифференциальная диагностика ЖДА и АХЗ

Индекс ферритина (Thomas C. and Thomas L. )

Нормохромные нормоцитарные анемии

Анемия при ХПН n n n Клеточность костного мозга в большинстве случаев ХПН остается нормальной. В зависимости от степени снижения продукции эндогенного эритропоэтина (э. ЭПО) отмечается нормальное или сниженное содержание эритрокариоцитов. Повышение количества ШИК-положительных эритроидных клеток у больных ХПН подтверждает наличие неэффективного эритропоэза. В периферической крови выявляется нормохромная нормоцитарная, реже гипохромная микроцитарная анемия, пойкилоцитоз различной степени выраженности с преобладанием эхиноцитов. Количество ретикулоцитов - обычно нормальное или незначительно снижено. Лечение больных ХПН препаратами рекомбинантного эритропоэтина приводит к частичной коррекции анемии, однако вследствии стимуляции эритропоэза может развиться ЖДА.

Макроцитарные анемии

Hb↓, RBC↓ MCV-↑, MCH-↑ , MCHC-N, RDW- ↑

Мегалобластическое кроветворение наблюдается: n n n Дефиците витамина В 12 Дефиците фолиевой кислоты Острый эритромиелоз Миелодиспластический синдром Применение цитостатиков-антиметаболитов (метотрексат, 6 -меркаптопурин, АРА-С и др. ) n Оротовая ацидурия ( у детей - наследственный дефицит ферментов, участвующих в метаболизме оротовой кислоты)

Перенос витамина В 12 в организме.

Биохимические процессы, идущие с участием витамина В 12.




Причины дефицита витамина В-12. n Нарушение всасывания - отсутствие внутреннего фактора Касла( атрофический гастрит, резекция желудка, облучение желудка) - поражение тонкого кишечника (энтерит, дисбактериоз, резекция тощей кишки, целиакия и т. д. ) n n Недостаточное поступление с пищей Конкурентное поглощение (широкий лентец, лямблиоз, патологическая микрофлора при наличии дивертикулеза или «слепой петли» ) n Повышенная утилизация витамина В 12 (злокачественные новообразования, гипертиреодизм) n Наследственный дефицит транскобаламина

Клиническкая картина дефицита витамина В 12. n n n Кроветворение: АНЕМИЯ, ЛЕЙКОПЕНИЯ, ТРОМБОЦИТОПЕНИЯ В РЕЗУЛЬТАТЕ МЕГАЛОБЛАСТИЧЕСКОГО ГЕМОПОЭЗА, ЖЕЛТУШНОСТЬ КОЖНЫХ ПОКРОВОВ, ГИПЕРБИЛИРУБИНЕМИЯ, УВЕЛИЧЕНИЕ ПЕЧЕНИ ВСЛЕДСТВИЕ НЕЭФФЕКТИВНОГО ЭРИТРОПОЭЗА Желудочно-кишечный тракт: ГЛОССИТ, СНИЖЕНИЕ СЕКРЕЦИИ, ОТСУТСТВИЕ АППЕТИТА, ДИСПЕПСИЯ, ПРИВОДЯЩАЯ К ПОТЕРЕ ВЕСА Нервная система: ПАРЕСТЕЗИИ, ОЩУЩЕНИЕ «ВАТНЫХ НОГ» , АТАКСИЧЕСКАЯ (СПАСТИЧЕСКАЯ) ПОХОДКА, ПАРАПАРЕЗЫ И ПАРАПЛЕГИИ, РАДИКУЛЯРНЫЕ БОЛИ, ПСИХОЗЫ.

Лабораторная диагностика В 12 -дефицитной анемии. n n Клинический анализ крови анемия, лейкопения, тромбоцитопения; ретикулоциты ниже 1, 2%; гиперхромия, макроцитоз эритроцитов (MCV более 100 fl, MCH более 32 пг, увеличение RDW ); ускоренное СОЭ. Мазок крови макро-, мегалоцитоз, шизоцитоз; базофильная пунктация эритроцитов, тельца Жолли, кольца Кебота в эритроцитах, нормобластоз; гиперсегментация ядер

Анализ периферической крови при В 12 -дефицитной анемии 12 RBC Hb MCV MCHC RDW 2. 45 x 10 /л 100 г/л 123. 7 fl 40. 8 пг 330 г/л 18. 3 % макроцитоз, гиперхромия эритроцитов, встречаются эритроциты с базофильной пунктацией
Периферическая кровь при мегалобластной анемии

Периферическая кровь при мегалобластной анемии

Периферическ ая кровь при мегалобластно й анемии

Костный мозг при В 12 -дефицитной анемии Костный мозг гиперплазия эритроидного ростка, мегалобластический эритропоэз, причудливые ядра нормобластов, кариорексис, дистрофические явления, гигантизм и уродливость клеток гранулоцитарного ряда n Исследование концентрации витамина В 12 в сыворотке крови вит. В 12 - ниже 148 пмоль/л у больных до 60 лет вит. В 12 - ниже 80 пмоль/л у больных старше 60 лет n

Костный мозг при мегалобластной анемии

Костный мозг при мегалобластной анемии

Костный мозг при мегалобластной анемии

Костный мозг при мегалобластной анемии

Фолиеводефицитная анемия • Запасы в организме – 5 -10 мг. • При отсутствии поступления – истощаются через 34 месяца • Суточная потребность – 50 -100 мкг. • 50% фолатов разрушается при термической обработке пищи. • В крови связывается с различными белками ( 2 -макроглобулином, альбумином) • Запасается в печени в виде полиглутаматов • Участвует в процессах пролиферации клеток (синтез пуриновых оснований)

Причины развития фолиеводефицитной анемии • Снижение содержания в пище (алкоголизм, голодание, длительная термическая обработка пищи) • Нарушение всасывания (хр. энтерокаллит, резекция тонкой кишки, диабетическая энтеропатия, целиакия, амилоидоз и т. д. ) • Повышенная потребность (беременность; гемолотические анемии, лейкозы, рак, туберкулез, гипертиреоз) • Уменьшение запасов в печени (алкоголизм, цирроз, гепатоцеллюлярный рак) • Прием лекарственных препаратов (цитостатики, контрацептивы, противосудорожные, противотуберкулезные препараты)


Гемолитические анемии

Внутриклеточный гемолиз ПЕЧЕНЬ Билирубин Биливердин (восстановление NADFH) Глобин (расщепление до аминок-т) Билирубин непрямой + альбумин КРОВОТОК Билирубин + Глюкуроновая кислота Прямой билирубин V. porta Уробилиноген Вердоглобин (отщепление Fe 3+и глобина) Met. Hb МФ СЕЛЕЗЕНКИ Почки Уробилиноиды мочи Стеркобилиноген Стеркобилин КИШЕЧНИК

Внутриклеточный гемолиз Анемия Увеличение селезенки Гиперплазия эритроидного ростка костного мозга Желтуха Увеличение печени Нормохромная нормоцитарная (MCV=N, MCHC=N) Ретикулоциты более 1, 2% Повышен непрямой билирубин Увеличен стеркобилин кала Увеличены уробилиноиды мочи

Патологический внутриклеточный гемолиз возникает при: n n n наследственной неполноценности мембраны эритроцита (эритроцитопатии) нарушении синтеза гемоглобина (гемоглобинопатии) нарушении синтеза ферментов – энзимопатии (дефицит ПК, тяжелая гипофосфатемия, дефицит пиримидин-5 -нуклеотидазы) избыточном количестве эритроцитов (физиологическая желтуха, эритробластоз новорожденного, эритремия – при количестве эритроцитов более 6 -7 x 1012/л). приобретенных аутоиммунных гемолитических анемиях (с агглютининами)

Внутрисосудистый гемолиз Фагоцитоз Hb Гемолиз в почки Hb, задержанный в канальцах Гаптоглобин Hb связывается. Гем катаболизируется Альбумин Гемопексин Диссоциация на глобин и гем Hb, выделяемый с мочой Гем связывается Ретикулоэндотелиальная система Эритроциты Hb окислятся в Met. Hb Фагоцитоз

Внутрисосудистый гемолиз Анемия Нормохромная нормоцитарная (MCV=N, MCHC=N) Гиперплазия эритроидного ростка костного мозга Ретикулоциты более 1, 2% Гемоглобинурия Моча темно-красная, черная Белок значительно повышен Проба на кровь резко положительна В осадке эритроцитов нет, гемосидерин Свободный гемоглобин плазмы Более 3 мг/100 мл (ОБЫЧНО ОКОЛО 100 мг/100 мл)

Патологический внутрисосудистый гемолиз возникат при: n n n токсических, механических, радиационных, инфекционных повреждениях мембраны эритроцитов, пароксизмальной ночной гемоглобинурии, эритроцитарных энзимопатиях (дефицит Г 6 ФДГ) паразитозах, в частности, малярии, приобретенных аутоиммунных гемолитических анемиях (гемолизины), пострансфузионных осложнениях, несовместимости по групповому или резус-фактору, переливании донорской крови с высоким титром антиэритроцитарных антител и других заболеваниях.

Костный мозг при гемолитических анемиях n n n обычно гиперклеточный с резко выраженной гиперплазией эритроидного ростка (до 60 -70 % от всех миелокариоцитов). созревание эритробластов не нарушено, выход эритроцитов в сосудистое русло идет ускоренными темпами. при интенсивном кроветворении после тяжелого гемолитического криза в костном мозге могут наблюдаться мегалобласты, очевидно, как следствие недостаточности витамина В 12 или усиленного расхода фолиевой кислоты.

Классификация ГА I. НАСЛЕДСТВЕННЫЕ Гемолитические Анемии 1. ГА, связанные с нарушением мембраны эритроцитов (эритроцитопатии) n Наследственный микросфероцитоз (б-нь Минковского-Шоффара) n Наследственный элиптоцитоз (овалоцитоз) n Наследственный стоматоцитоз n Наследственная - -липопротеинемия (акантоцитоз) 2. Гемоглобинопатии n Количественные (Талассемии) n Качественные, связанные с нарушением структуры цепей гемоглобинов (СКА, анемии, обусловленные носительством нестабильных гемоглобинов и т. д. ) 3. ГА, связанные с нарушением активности ферментов эритроцитов (энзимопатии) n ГА, обусловленные дефицитом активности Г-6 -ФД n ГА, обусловленные дефицитом активности пируваткиназы n ГА, обусловленные дефицитом активностиглютатионредуктазы n

Наследственные гемолитичесие анемии Мембранные дефекты нарушение белковой структуры (наследственный сфероцитоз, эллиптоцитоз, стоматоцитоз) Патогенез: дефект Na+-K+-АТФазы нарушение электролитного баланса набухание эритроцитов снижением осмотической резистентности гемолиз в селезенке дефект липидной части мембраны при а- липопротеинемии

Клинические проявления б-ни Минковского-Шоффара n n n Наследуется по аутосомно- рецессивному типу, Гемолитический синдром, проявляющийся желтухой, спленомегалией и анемией. В детском возрасте развивается деформация скелета, особенно черепа, рано отмечается увеличение селезенки, общая отсталость развития. При гетерозиготной форме заболевания клинические признаки слабо выражены, но имеют место характерные морфологические изменения эритроцитов (микросфероцитоз). Гемолитический криз возникает под влиянием провоцирующих факторов (инфекция, переохлаждение, переутомление, беременность и др. ). Микросфероцитарная гемолитическая анемия имеет хроническое течение, сопровождается периодическими кризами и ремиссиями.

В периферической крови эритроциты (микросфероциты) характеризуются : § небольшим диаметром (в среднем 5 мкм), § средняя толщина увеличена до 2, 5 -3, 0 мкм, сферический индекс (СФ) - отношение диаметра (d) эритроцита к его толщине ( Т ) снижен в среднем до 2, 7 ( при норме 3, 4 -3, 9). § содержание гемоглобина в эритроцитах в пределах нормы или несколько выше ее. § количество микросфероцитов в период ремиссии и при латентной форме болезни не бывает высоким, в то время как гемолитический криз может сопровождаться увеличением их до 30% и выше. § морфологически микросфероциты имеют небольшой размер, гиперхромны без центрального просветления § одним из характерных признаков заболевания является снижение осмотической устойчивости эритроцитов.

Различают -талассемию и -талассемию: -талассемия – дефект синтеза -цепи (отсутствует м. РНК в гене -цепи глобина). Выделено 4 гена и в зависимости от нарушения, выделяют 4 основные формы -талассемии: гомозиготная -талассемия, Н-гемоглобинопатия, малая -талассемия ( -th 1), бессимптомная форма -талассемии ( -th 2). Картина крови и костного мозга аналогичны -талассемии. -таласемия – отсутствие или нарушение строения -цепи (м. РНК мало или дефектная). Выделяют 2 вида: - гомозиготная – большая таласемия, анемия Кули (тяжелое течение, больные трансфузионнозависимые); - гетерозиготная – малая талассемия (легкая форма, с редкими кризами) Диагностика: высокое содержание Hb. F и Hb. A 2

Классификация ГА n 1. 2. n n I. ПРИОБРЕТЕННЫЕ Гемолитические Анемии ГА, связанные с воздействием АТ(иммунные) Аутоиммунные ГА 1. АИГА против АГ эритроцитов периферической крови АИГА с неполными тепловыми агглютитинами АИГА с тепловыми гемолизинами АИГА с полными холодовыми агглютининами Пароксизмальная холодовая гемоглобинурия 2. Парциальная красноклеточная аплазия 3. Болезнь Маркиафавы – Микели (пароксизмальная ночная гемоглобинурия) 4. ГА, связанные с механическим повреждением эритроцитов n Механический гемолиз при протезировании сосудов или клапанов сердца n Маршевая гемоглобинурия

Приобретенные гемолитические анемии ГА, обусловленне воздействием АТ 1. Изоиммунные ГА 2. Аутоиммунные ГА 1. АИГА против АГ эритроцитов периферической крови n АИГА с неполными тепловыми агглютитинами n АИГА с тепловыми гемолизинами n АИГА с полными холодовыми агглютининами n Пароксизмальная холодовая гемоглобинурия 2. Парциальная красноклеточная аплазия




Благодарю за внимание!

Транспорт железа Трансферрин n Транспортный белок ( -1 -глобулин), гликопротеин, 2 центра связывания, 88 к. Да. n Переносит Fe из ЖКТ к эритрокариоцитам и в тканевые депо (печень и др. ). n Нормальный уровень: 2, 6 0, 05 г/л. n Насыщение трансферрина железом: 3075%. n Поступает в клетку путем эндоцитоза: захват клеткой комплекса Fe-трансферрин.

Обмен железа в организме

Кинетика эритрона.

Коэффициент вариации подсчета ретикулоцитов RET% 9% 1% Ручной метод (CV%) 27, 2 47, 3 Гематологический анализатор (CV%) 5, 8 6, 4
f9ecdb6c5615610137011814d2e07bf4.ppt